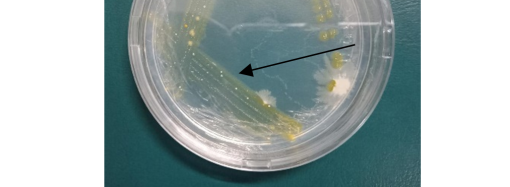

Pengenalan Tipe Gejala dan Tanda Penyakit yang Disebabkan Oleh Bakteri dan Fitoplasma
- Hama Penyakit Tanaman, Pengetahuan Pertanian
- Juni 22, 2024
Tanaman yang dibudidayakan selama perkembangan dan pertumbuhannya akan mendapat banyak gangguan dari lingkungan sekitar baik abiotik maupun biotik, salah satunya dari penyakit atau patogen penyebab timbulnya penyakit pada tanaman. Tanaman memiliki tingkat ketahanan terhadap penetrasi dari patogen yang tergantung pada jenis tanaman dan gen tanaman itu sendiri. Tanaman yang rentan akan mudah terinfeksi oleh patogen dan timbul gejala penyakit, oleh karena itu kehilangan hasil dan kerugian ekonomi akan terjadi jika tidak ada penanggulangan atau tindakan pengendalian penyakit pada tanaman. Salah satu pengendalian yang baik digunakan dengan pengendalian hayati yang memanfaatkan agens hayati yang ada di lingkungan sekitar maupun introduksi dari luar. Pengendalian hayati merupakan tindakan yang bertujuan mengurangi jumlah inokulum atau aktivitas timbulnya penyakit oleh patogen terhadap tanaman.
Agens hayati sebagai pengendali patogen penyebab penyakit saat ini banyak dikembangkan, seperti Pseudomonas sp., Nigrospora sp., Chaetomium sp., Cryptococcus sp., dan masih banyak lagi. Karakteristik setiap jenis agens hayati baik cendawan maupun bakteri memberikan peranan yang berbeda dalam, baik dalam cara mengendalikan maupun tempat atau target patogen yang dikendalikan. Oleh karena itu, penentuan target yang akan dikendalikan akan menentukan cara dan jenis agens hayati yang digunakan. Hasil beberapa pengujian dan identifikasi setiap jenis agens hayati memiliki karakteristik tersendiri, baik itu bentuk koloni, warna koloni, hifa, spora dan miselium serta ukuran koloni. Berikut beberapa agens hayati yang diamati :
Khamir atau yeast adalah cendawan bersel satu yang tidak berflagel yang hidupnya bisa menjadi saprofit maupun parasitik (Sumarsih 2003). Khamir bisa ditemukan diberbagai tempat atau lingkungan, seperti di dalam tanah, di daun tanaman, dan tempat-tempat yang terdapat gula, asam, dan garam (Widiastutik dan Alami 2014). Salah satu jenis khamir yang mudah ditemui yaitu Cryptococcus albidus, jenis yeast ini memiliki beberapa ciri diantaranya koloni berwarna putih sampai krem. Pengamatan dengan mikroskop cahaya perbesaran 40×10 terlihat sel Cryptococcus albidus, bentuk spora bulat sedikit lonjong dan transparan.

Bakteri yang bisa dimanfaatkan sebagai agens hayati adalah Pseudomonas sp., Pseudomonas merupakan salah satu genus dari Famili Pseudomonadaceae. Bakteri banyak ditemukan pada ekosistem tanah rhizosfer, bakteri ini mampu hidup dan berkembang di tanah dengan memanfaatkan senyawa organik dan anorganik. Bakteri Pseudomonas sp. kelompok fluoresen dapat memproduksi IAA, sitokinin, isopentenyl adenosine, dan zeatin ribose (Salamone et al. 2001). Pseudomonas sp. juga diketahui memproduksi asam silikat yang mampu mengendalikan Tobacco necrosis virus pada tembakau (Maurhofer et al.1994). Chrisnawati et al. (2017) menyatakan dalam penelitiannya bebrapa isolat dari Pseudomonas sp. memiliki kemampuan dalam mengkolonisasi patogen dengan mekanisme siderofor dan antibiosis mampu menghambat perkembangan patogen.
Hasil pengamatan pada saat praktikum hanya sebatas pengamatan makroskopis, Pseudomonas sp. pada terlihat koloni berwarna kuning dan berlendir. Salah satu spesies Pseudomonas yang banyak digunakan adalah Pseudomonas fluorescens yang telah teruji mampu mengenekan dan mengendalikan patogen Fusarium oxysporum penyebab layu pada tanaman. Penelitian Santoso et al. (2007) mengungkapkan bahwa Pseudomonas fluorescens menghambat timbulnya penyakit dan gejala pada tanaman bawang merah, serta mampu menurunkan tingkat keparahan penyakit akibat patogen Fusarium oxysporum. Selain itu, Pseudomonas sp. berperan sebagai Plant Growth Promoting Rhizobacteria (PGPR).
Nigrospora merupakan cendawan yang termasuk ke dalam kelas Deuteromycetes, cendawan ini merupakan agens hayati yang mampu menghasilkan antimikroba dan menginduksi ketahanan tanaman dari patogen. Pengamatan yang dilakukan terlihat Nigrospora memiliki koloni berwarna hitam, yang pada awalnya putih berubah menjadi hitam (Gambar 3). Pengamatan melalui mikroskop dengan perbesaran lensa 40×10 diperoleh bentuk kondia bulat berwarna hitam.

Chaetomium merupakan cendawan yang termasuk dalam kelas Sordariomycetes dan dalam famili Chaetomiaceae. Cendawan ini dapat ditemukan di tanah udara, sisa-sisa tanaman mati. Chaetomium memiliki koloni berwarna hitam ke abu-abuan dan terdapat miselium halus. Pengamatan dengan menggunakan mikroskop cahaya pada perbesaran lensa 10×10 terlihat adanya askospora (spora dan hifa).
Chaetomium merupakan cendawan endofit yang bisa digunakan dalam pengendalian penyebab penyakit, Chaetomium memiliki kemampuan dalam memecah atau mendegradasi dinding sel patogen dan menghilangkan patogenesitas dari patogen (Vilavong & Soytong 2017), mekanisme dalam menghambat patogen juga memproduksi antibiotik termasuk rotiorinol A, dan C, rotiorinol dan epi-isochromophilone II.

Chrisnawati, Sudjijo, Marlen L, Nasrun. 2017. Evaluasi Antagonis Pseudomonas fluorescens dalam Mengendalikan Penyakit Layu Fusarium pada Tomat. PROS SEM NAS MASY BIODIV INDON. 3 (2): 273-277. Doi : 10.13057/psnmbi/m030219.
Fitriati Y, Wiyono S, Sumarauw IO. 2014. Khamir antagonis untuk pengendalian penyakit antraknosa pada buah avokad selama penyimpanan. Jurnal Fitopatologi Indonesia. 9(5):153.
Puspitasari AE, Abadi AL, Sulistyowati L. 2014. Potensi Khamir sebagai Agens Pengendali Hayati Patogen Colletotrichum sp. Pada Buah Cabai, Buncis, dan Strowberi. Jurnal HPT. 2(3);92-101.
Santoso SE, Soesanto L, Haryanto TAD. 2007. Penekanan hayati penyakit moler pada bawang merah dengan Trichoderma harzianum, Trichoderma koningii, dan Pseudomonas fluorescens P60. Jurnal Hama dan Penyakit Tumbuhan Tropika. 7(1):53-61.
Sumarsih S. 2003. Mikrobiologi Dasar. Jurusan Ilmu Tanah. Fakultas Pertanian UPN Yogyakarta [Diktat Kuliah]. Yogyakarta.
Vilavong S, Soytong K. 2017. Application of A New Bio-Formulation of Chaetomium cupreum For Biocontrol of Colletotrichum gloeosporioides Causing Coffee Anthracnose on Arabica Variety in Laos. AGRIVITA, Journal of Agricultural Science. 39(3):303-310. doi:https://agrivita.ub.ac. id/index.php/agrivita/article/viewFile/1070/875.
Widiastutik N, Alami NH. 2014. Isolasi dan Identifikasi Yeast dari Rhizosfer Rhizophora mucronataWonorejo. JURNAL SAINS DAN SENI POMITS. 3(1);2337-3520.
Portal Agrikultur Indonesia
Jl. Raya Solo - Yogyakarta
Klaten
Jawa Tengah 57452
Wa: 62 852-9323-7076
Email: info@agropawarto.com



